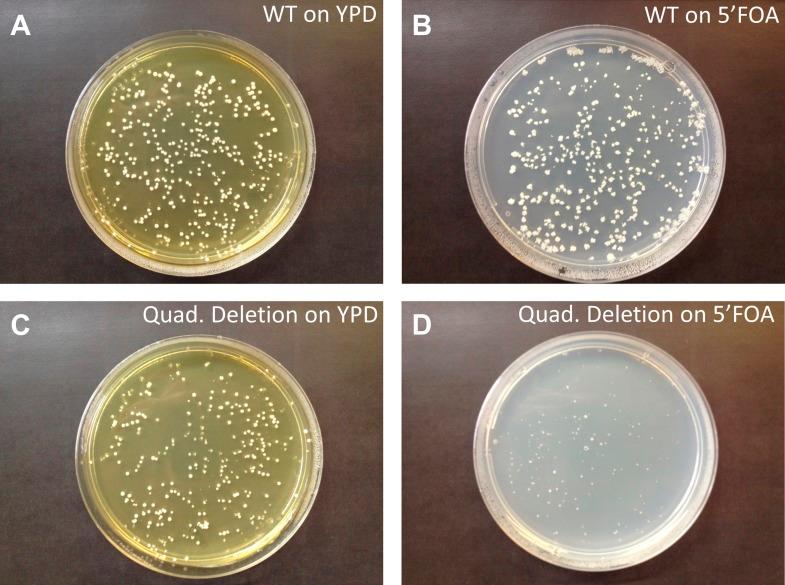

转运RNA基因在进化过程中迅速变化,以满足新的翻译需求。
tRNA genes rapidly change in evolution to meet novel translational demands.
作者信息
Yona Avihu H, Bloom-Ackermann Zohar, Frumkin Idan, Hanson-Smith Victor, Charpak-Amikam Yoav, Feng Qinghua, Boeke Jef D, Dahan Orna, Pilpel Yitzhak
机构信息
Department of Molecular Genetics, Weizmann Institute of Science, Rehovot, Israel.
出版信息
Elife. 2013 Dec 20;2:e01339. doi: 10.7554/eLife.01339.
Changes in expression patterns may occur when organisms are presented with new environmental challenges, for example following migration or genetic changes. To elucidate the mechanisms by which the translational machinery adapts to such changes, we perturbed the tRNA pool of Saccharomyces cerevisiae by tRNA gene deletion. We then evolved the deletion strain and observed that the genetic adaptation was recurrently based on a strategic mutation that changed the anticodon of other tRNA genes to match that of the deleted one. Strikingly, a systematic search in hundreds of genomes revealed that anticodon mutations occur throughout the tree of life. We further show that the evolution of the tRNA pool also depends on the need to properly couple translation to protein folding. Together, our observations shed light on the evolution of the tRNA pool, demonstrating that mutation in the anticodons of tRNA genes is a common adaptive mechanism when meeting new translational demands. DOI: http://dx.doi.org/10.7554/eLife.01339.001.
当生物体面临新的环境挑战时,例如在迁移或基因变化之后,表达模式可能会发生改变。为了阐明翻译机制适应此类变化的机制,我们通过删除tRNA基因来扰动酿酒酵母的tRNA库。然后我们使缺失菌株进化,并观察到遗传适应反复基于一种策略性突变,该突变改变了其他tRNA基因的反密码子以与缺失的tRNA基因的反密码子相匹配。引人注目的是,在数百个基因组中的系统搜索表明,反密码子突变发生在整个生命树中。我们进一步表明,tRNA库的进化还取决于将翻译与蛋白质折叠正确耦合的需求。总之,我们的观察结果揭示了tRNA库的进化,表明当遇到新的翻译需求时,tRNA基因反密码子中的突变是一种常见的适应性机制。DOI: http://dx.doi.org/10.7554/eLife.01339.001